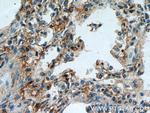
PIP5K1B Antibody in Immunohistochemistry (Paraffin) (IHC (P))

Search
Proteintech
PIP5K1B Polyclonal Antibody
{{$productOrderCtrl.translations['antibody.pdp.commerceCard.promotion.promotions']}}
{{$productOrderCtrl.translations['antibody.pdp.commerceCard.promotion.viewpromo']}}
{{$productOrderCtrl.translations['antibody.pdp.commerceCard.promotion.promocode']}}: {{promo.promoCode}} {{promo.promoTitle}} {{promo.promoDescription}}. {{$productOrderCtrl.translations['antibody.pdp.commerceCard.promotion.learnmore']}}
产品信息
12541-1-AP
种属反应
已发表种属
宿主/亚型
分类
类型
抗原
偶联物
形式
浓度
规格
纯化类型
保存液
内含物
保存条件
运输条件
产品详细信息
Immunogen sequence: SEGSNLTPA HHYPDFRFKT YAPLAFRYFR ELFGIKPDDY LYSICSEPLI ELSNPGASGS LFFVTSDDEF IIKTVQHKEA EFLQKLLPGY YMNLNQNPRT LLPKFYGLYC MQSGGINIRI VVMNNVLPRS MRMHFTYDLK GSTYKRRASR KEREKSNPTF KDLDFLQDMH EGLYFDTETY NALMKTLQRD CRVLESFKIM DYSLLLGIHF LDHSLKEKEE ETPQNVPDAK RTGMQKVLYS TAMESIQGPG KSGDGIITEN PDTMGGIPAK SHRGEKLLLF TGIIDILQSY RLMKKLEHSW (107-405 aa encoded by BC030587)
靶标信息
PIP5K1B lipid kinase or phosphatidylinositol-4-phosphate 5-kinase, type I, beta is a member of the phosphatidylinositol-4-phosphate 5-kinase family. PIP5K1B gene contains 17 exons and spans more than 300 kb. The seventeenth exon was found by RT-PCR, and is derived from the 3-prime untranslated region of the PRKACG gene which is located on 9q13 approximately 3 kb downstream of the STM7.I 3-prime untranslated region. The overexpression of PIP5K1B in COS-7 cells induces an increase in short actin fibers and a decrease in actin stress fibers.
仅用于科研。不用于诊断过程。未经明确授权不得转售。
生物信息学
蛋白别名: 68 kDa type I phosphatidylinositol 4-phosphate 5-kinase beta; Phosphatidylinositol 4-phosphate 5-kinase type I alpha; Phosphatidylinositol 4-phosphate 5-kinase type I beta; Phosphatidylinositol 4-phosphate 5-kinase type-1 beta; phosphatidylinositol-4-phosphate 5-kinase; phosphatidylinositol-4-phosphate 5-kinase type I alpha; phosphatidylinositol-4-phosphate 5-kinase type I beta; phosphatidylinositol-4-phosphate 5-kinase type-1 beta; phosphatidylinositol-4-phosphate 5-kinase, type 1 alpha; phosphatidylinositol-4-phosphate 5-kinase, type 1, beta; PIP5K1-beta; PIP5KI-beta; PIP5KIalpha; PIP5KIB2 protein; PIP5KIbeta; Protein STM-7; ptdIns(4)P-5-kinase 1 beta; ptdIns(4)P-5-kinase beta; STM-7 protein; Type I phosphatidylinositol 4-phosphate 5-kinase beta; unnamed protein product
基因别名: MSS4; PI4P5K-I[b]; PIP5K1-beta; Pip5k1a; PIP5K1B; PIP5KIbeta; Pipk5b; STM7
UniProt ID: (Human) O14986, (Mouse) P70181, (Rat) Q5CZZ9
Entrez Gene ID: (Human) 8395, (Mouse) 18719, (Rat) 309419